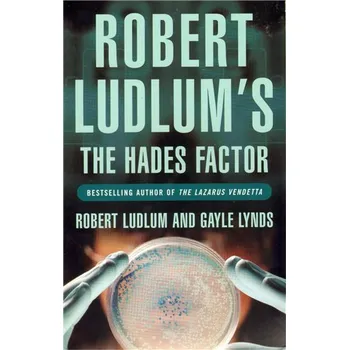
The Hades Factor

Child Garden - Ryman, Geoff
- Rok vydání 1990
Winner of the Arthur C. Clarke Award 1990 and the John W. Campbell Memorial Award 1990.…
v 3 obchodech

Winner of the Arthur C. Clarke Award 1990 and the John W. Campbell Memorial Award 1990.…
v 3 obchodech

Buckle up for this sizzling grumpy/sunshine small-town romance that will throw a lasso around your heart and have you…
v 5 obchodech

Kniha - 368 stran, anglicky, brožovaná bez přebalu matná…
Alza.cz
![Outlawed - North Anna [EN] (2022, Měkká, Orion Publishing Co)](https://d25-a.sdn.cz/d_25/c_img_gX_CR/4h0B2Ul.jpeg?fl=res%2C350%2C350%2C1%2Cfff%7Cwebp%2C80)
\n\'A feminist Western about a world in which women\'s worth and right to live are determined by the vagaries of fertility.…
v 2 obchodech

\n\'One of the penalties for refusing to participate in politics is that you end up being governed by your inferiors\'…
MEGAKNIHY.cz

Three years ago, Lift asked a goddess to stop her from growing older--a wish she believed was granted. Now, in Edgedancer,…
Luxor.cz

Girl on Girl looks at how women are using photography, the internet and the female gaze to explore self-image and female…
Enbook.cz

Autor : Andrzej Sapkowski, Popis : The adventures of Geralt the Witcher continue in this second novel in the bestselling…
v 2 obchodech

Autor : Bettany Hughes, Popis : Their names still echo down the ages: The Great Pyramid at Giza. The Hanging Gardens of…
Palmknihy.cz

The official history of British Vogue, telling the magazine's story and how it has reflected the changing face of Britain…
Ajshop.cz

The Witcher, Geralt of Rivia, holds the fate of the world in his hands in the New York Times bestselling first novel in the…
v 2 obchodech
A homeless man in Boston, an Army Major in California, and a teenage girl in Atlanta all die suddenly and painfully - each a…
v 4 obchodech

Enter the world of Brandon Sanderson and discover the international fantasy phenomenon with a continuation of his acclaimed…
v 2 obchodech

THE MOST IMPORTANT CASE OF HIS LIFE. ONLY THIS TIME THE DEFENDANT IS HIMSELF. 'This is Connelly on top form .. . A terrific…
v 4 obchodech

From Number One bestseller Michael Connelly, author of The Poet and The Lincoln Lawyer, comes a new edition of the first…
v 4 obchodech

He's my dark Romeo... but this isn't a love story.It was supposed to be a harmless kiss at a lavish debutante ball.A…
v 12 obchodech

My brother's best friend broke my heart... what happens when his new teammate wants to put it back together?For years, I've…
v 12 obchodech

Kniha - 320 stran, anglicky, brožovaná bez přebalu matná…
v 5 obchodech

A city on the brink. A mother on the edge. A nightmare that only DI Helen Grace can end.Sometimes, the darkest secrets hide…
v 5 obchodech

Buckle up for this sizzling grumpy/sunshine small-town romance that will throw a lasso around your heart and have you…
v 3 obchodech

Kniha - 400 stran, anglicky, brožovaná bez přebalu matná The Sanderson book for readers who have never picked up a Sanderson…
v 2 obchodech

The Witcher, Geralt of Rivia, holds the fate of the world in his hands in the New York Times bestselling first novel in the…
v 4 obchodech

Kniha - autor Wally Koval, 368 stran, anglicky, pevná bez přebalu lesklá Wes Anderson's beloved films announce themselves…
v 2 obchodech

\nBeauty is a weapon - and Fire is going to use it...\n…
v 3 obchodech

Englishbooks.cz

Englishbooks.cz

World War Terminus had left the Earth devastated. Through its ruins, bounty hunter Rick Deckard stalked, in search of the…
v 3 obchodech

In a small-town high school in 1988, three misfit girls join forces to form the Bitch Goddesses, a take-no-prisoners gang of…
Englishbooks.cz

'If Gossip Girl and Made in Chelsea had a baby, it would be this book.' (FIVE STAR READER REVIEW)'How many loves do you get…
v 4 obchodech

The Sheedy sisters had lived in Stone House for as long as anyone could remember. Set high on the cliffs on the west coast…
Englishbooks.cz

\n\'War does not determine who is right - only who is left\' Bertrand RussellA fascinating and engaging introduction to one…
MEGAKNIHY.cz

Ten gripping stories from ten bestselling authors…
MEGAKNIHY.cz

CAN GREECE RESIST THE MIGHT OF ROME? Get ready for the climax of the Roman invasion of Greece in Sunday Times bestseller Ben…
MEGAKNIHY.cz
![Syria's Secret Library - Thomson, Mike [EN] (2019, Brožovaná, Orion Publishing Group)](https://d25-a.sdn.cz/d_25/c_img_oW_BG/nO1SBfAluiUs1X7WCZ8cSq/731c.jpeg?fl=res%2C350%2C350%2C1%2Cfff%7Cwebp%2C80)
MEGAKNIHY.cz
![I'll Be You - Janelle Brown [EN] (2022, Měkká, Orion Publishing Co)](https://d25-a.sdn.cz/d_25/c_img_oW_p/kObgaqJNMnDMhdn0bCVQiIf/7b73.jpeg?fl=res%2C350%2C350%2C1%2Cfff%7Cwebp%2C80)
\nTwo identical twin sisters and former child actors have grown apart-until one disappears, and the other is forced to…
MEGAKNIHY.cz

Robbie and Emily they have been together for decades. Now, their joints are creaking and their eyesight is failing - but…
v 6 obchodech
![Tiny Pieces of Us - Pellegrino, Nicky [EN] (2021, Měkká, Orion Publishing Co)](https://d25-a.sdn.cz/d_25/c_img_oW_BG/kObgaqJNMnB0yvGzjCZ9CdF/f75d.jpeg?fl=res%2C350%2C350%2C1%2Cfff%7Cwebp%2C80)
\nHeartbreakingly romantic and deeply moving, Tiny Pieces of Us explores the wholly unexpected ways our lives can become…
MEGAKNIHY.cz

"Genuinely new, bold and fascinating. Anoushka Warden is a true talent." - Deborah Frances-White, author of The Guilty…
v 3 obchodech

A TAROT DECK FOR MUSIC LOVERS with the biggest stars representing the cards' meaningsAN ACCESSIBLE ENTRY TO TAROT or an…
Luxor.cz

A FUN, SIMPLE GAME of matching pairs, suitable for ages 6+. In the format of a classic memory game, Under the Sea will have…
Luxor.cz

originální anglická četba…
Ajshop.cz

Larkin (The Tribune) picks up the reins for the fifth entry in the Ludlum-spawned Covert-One biotech series (The Altman…
v 4 obchodech

The fifth of the Sunday Times Bestselling series sees PC Grant looking for missing children. And missing London. In the…
v 11 obchodech

A brilliant, gripping stand-alone novel from the SUNDAY TIMES bestselling author of I WILL FIND YOU'Dark, twisted and…
v 2 obchodech
![Living Dead In Dallas - Charlaine Harris [EN] (2011, Brožovaná, Orion Publishing Co)](https://d25-a.sdn.cz/d_25/c_img_oW_E/kObgaqJNMnB0llrc0COa98r/262a.jpeg?fl=res%2C350%2C350%2C1%2Cfff%7Cwebp%2C80)
The Golden Globe award-winning series, now showing on FX, the channel that brought us DEXTER.…
v 3 obchodech
![The Female Man - Russ, Joanna [EN] (2010, Brožovaná, Orion Publishing Co)](https://d25-a.sdn.cz/d_25/c_img_oW_BG/kObgaqJNMnD1IUpBBMCZ9iuF/077c.jpeg?fl=res%2C350%2C350%2C1%2Cfff%7Cwebp%2C80)
A landmark book in the fields of science fiction and feminism.…
v 3 obchodech
![Echo Park - Michael Connelly [EN] (2014, Brožovaná, Orion Publishing Co)](https://d25-a.sdn.cz/d_25/c_img_oW_BG/nO1SBfAluiBtflt23CZ9oiC/1ee5.jpeg?fl=res%2C350%2C350%2C1%2Cfff%7Cwebp%2C80)
Bosch reopens the hunt for a psychotic killer who stalked the streets of Los Angeles years before. The superb twelfth Harry…
v 2 obchodech

Genny is a rising star at spellcrackers.com: she finds the 'M' in magic - and that invariably leads to Mischief, Malice and…
Bookshop.cz